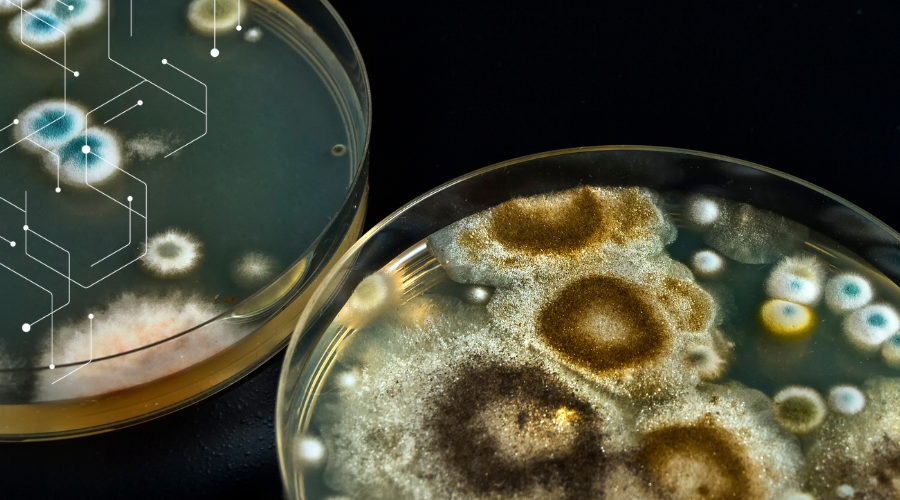

Digging Up Disease: Infection Prevention Strategies for Healthcare Construction Projects
Healthcare construction and remodeling projects can dramatically increase infection risks for vulnerable patients, staff, and visitors, but proactive environmental testing, planning, and rigorous infection control can keep your facility’s healing mission on track. In this post, we examine some of the primary infection risks in healthcare construction projects and offer risk mitigation strategies for each. […]
Digging Up Disease: Infection Prevention Strategies for Healthcare Construction Projects Read More »